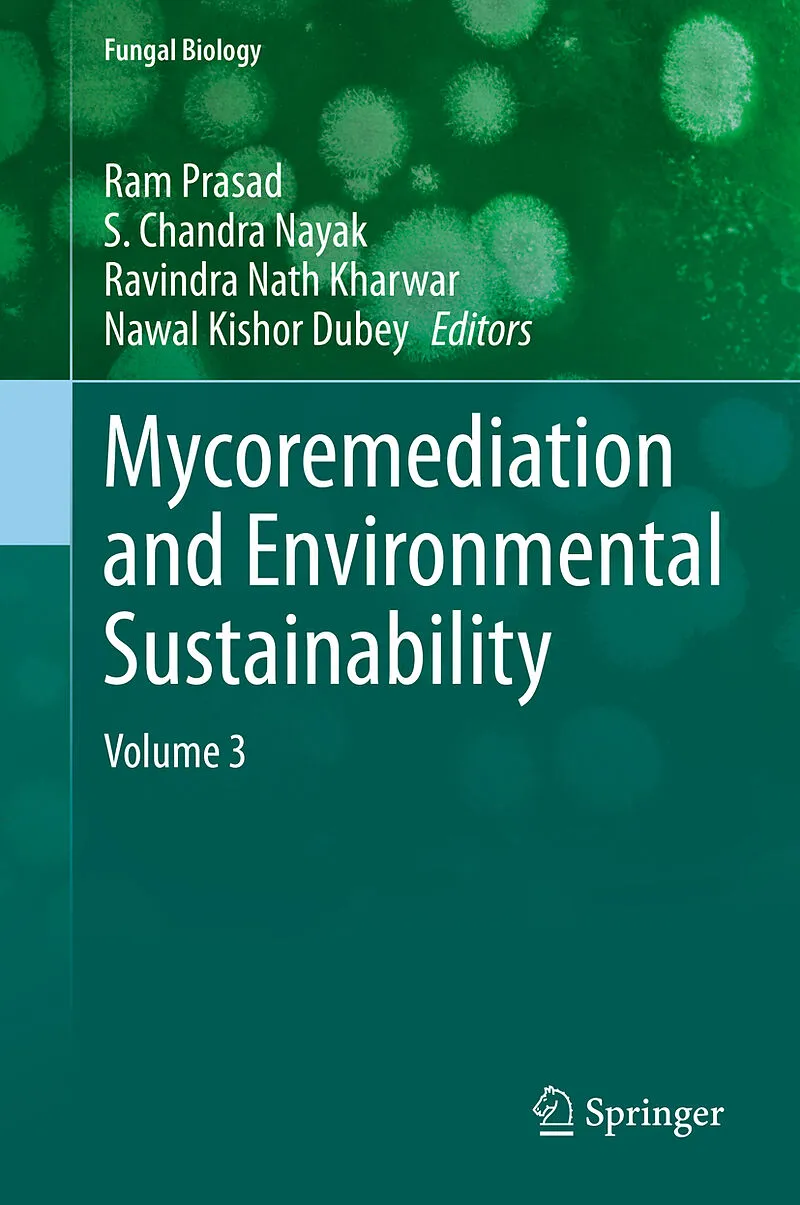

Mycoremediation and Environmental Sustainability
Beschreibung
Volume 3 covers recent research with expanded coverage on this important area of remediation. Mycoremediation is the form of bioremediation in which fungi-based technology is used to decontaminate the environment. Fungi are among the primary saprotrophic orga...
Format auswählen
- Fester EinbandCHF 172.40
- E-Book (pdf)CHF 189.90
- Kartonierter EinbandCHF 172.40
Wird oft zusammen gekauft
Andere Kunden kauften auch
Beschreibung
Volume 3 covers recent research with expanded coverage on this important area of remediation. Mycoremediation is the form of bioremediation in which fungi-based technology is used to decontaminate the environment. Fungi are among the primary saprotrophic organisms in an ecosystem, as they are efficient in the decomposition of organic matter. Wood-decay fungi, especially white rot, secretes extracellular enzymes and acids that break down lignin and cellulose. Fungi have been proven to be a very cost-effective and environmentally-friendly way for helping to remove a wide array of toxins from damaged environments or wastewater. These toxins include heavy metals, persistent organic pollutants, textile dyes, leather tanning industry chemicals and wastewater, petroleum fuels, polycyclic aromatic hydrocarbon, pharmaceuticals and personal care products, pesticides and herbicides, in land, fresh water and marine environments. Bioremediation of toxic organics by fungi is the most sustainable and green route for cleanup of contaminated sites and we discuss the multiple modes employed by fungi for detoxification of different toxic and recalcitrant compounds including prominent fungal enzymes viz., catalases, general lipase, laccases, peroxidases and sometimes intracellular enzymes, especially the cyrochrome P450 monooxygeneses.
Fungi play an important role in the biogeochemical cycling of manganese and other redox-active metals, which is related to their ability to survive radiation and other oxidative challenges.
This book covers recent research with more detail on the various types of fungi and associated fungal processes used to clean up wastes and wastewaters in contaminated environments, and discusses their potential for environmental applications.
Broadens reader comprehension of fungal biology and enzyme production in fungi Enriches understanding of mycoremediation and environmental applications of fungi Equips readers in the fields of microbiology and fungal biology with information to develop environmental policy
Autorentext
Dr. Ram PrasadMahatma Gandhi Central UniversityDepartment of BotanyMotihari, Bihar 845401Indiarpjnu2001@gmail.com; ramprasad@mgcub.ac.in+91-8745855570
S. Chandra NayakUniversity of MysoreDepartment of Studies in BiotechnologyManasagangotri, Mysore 570006Indiamoonnayak@gmail.com
Prof. Ravindra Nath KharwarBanaras Hindu UniversityDepartment of BotanyVaranasi, Uttar Pradesh 221005Indiarnkharwar@yahoo.com; rnkharwar@gmail.com+91-9415290001
Prof. Nawal Kishor DubeyBanaras Hindu UniversityDepartment of BotanyVaranasi, Uttar Pradesh 221005Indiankdubeybhu@gmail.com; nkdubey2@rediffmail.com+91-9415295765; +91 9838602197
Inhalt
Preface.- Bioremediation of Toxic Pesticides in Soil Using Some Microbial Products.- Microbial Enzymes in the Bioremediation of Polutants: Emerging Potential and Challenges.- Arbuscular Mycorrhizal Fungi and Remediation Potential of Soils Contaminated by Potentially Toxic Elements.- Nanotechnology and Bioremediation.- Mycoremediation through Redox Mechanisms of Organic Pollutants.- Role of Endophytes in Plant Associated Remediation and Plant Growth Promotion: A Deep Insight.- Microbial Remediation: A Natural Approach for Environmental Pollution Management.- Microbial Biocontrol Agents for Agricultural Soil Remediation: Prospects and Application.- Soil Bioremediation: An Insight into Available Green Technology and Future Developments.- Microbial Bioformulation Technology for Applications in Bioremediation.- Endophytic Fungi Interaction with Transgenic Plants.- Mycoremediation of Plastics for Efficient Waste Management: A Review.- Biotechnology of Beneficial Bacteria and Fungi Useful inAgriculture.- Index.